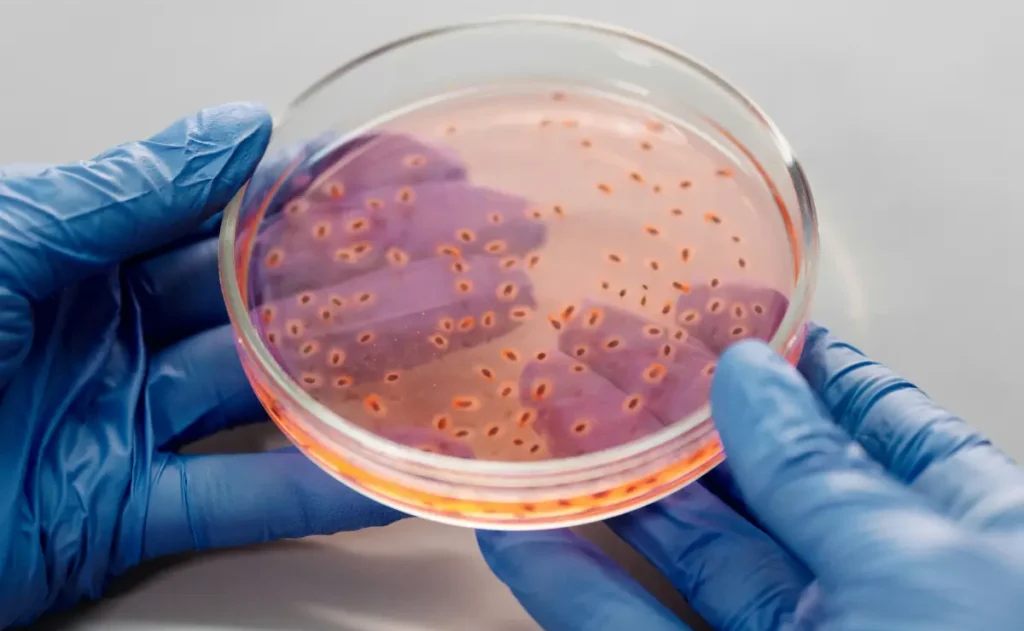

Luotettava elintarvikelaboratorio jo vuodesta 1997
Net-Foodlab oy:n laboratorio on palvellut elintarvikealan yrityksiä luotettavasti jo vuodesta 1997. Yli 25 vuoden kokemuksemme, FINAS-akkreditointi ja laaja asiantuntijaverkostomme tekevät meistä monipuolisen ja osaavan kumppanin elintarvikealan laboratoriotarpeisiin.
Tarjoamme laajan valikoiman mikrobiologisia ja kemiallisia tutkimuksia sekä erityisosaamista allergeenianalyyseistä, pintahygieniatutkimuksista ja tukipalveluista. Autamme koko analyysiprosessin hallinnassa:
Saat meiltä kaiken tarvittavan yhdestä paikasta asiantuntevasti ja joustavasti.
Kattavat laboratoriopalvelut elintarvikealan tarpeisiin
Mikrobiologiset ja kemialliset analyysit
Tutkimusmenetelmämme kattavat lähes kaikki elintarvikealan ja suurkeittiöiden yleisimmät analyysitarpeet. Ymmärrämme tuotantolaitosten toimintaympäristöt ja tarjoamme asiakkaillemme juuri heidän toimintaansa ohjaavaa tietoa

Allergeenijäämätutkimukset
Allergeenianalyysit ovat ydinosaamistamme. Toteutamme analyysit lähes poikkeuksetta omassa laboratoriossamme, mikä takaa tulosten nopeuden ja luotettavuuden. Käytämme akkreditoituja ja validoituja menetelmiä – tuloksiimme luottavat niin elintarviketeollisuuden toimijat kuin muut laboratoriotkin.

Pintahygieniatutkimukset ja puhtauden varmistus
Olemme olleet mukana varmistamassa elintarvikkeiden tuotannossa käytettävien tilojen turvallisuutta jo 25 vuoden ajan. Tarjoamme:
Toimimme valtakunnallisesti ja tarjoamme tarvittaessa myös näytteenottovälineet ja -palvelut
Tutustu tarjoamiimme laboratoriotutkimuksiin ja tutkimuspaketteihin täältä
Valmiit analyysipaketit – helppo ja nopea tapa aloittaa
Haluatko päästä nopeasti liikkeelle? Olemme koonneet valmiit analyysipaketit elintarviketeollisuuden ja suurkeittiöiden tarpeisiin. Paketit on suunniteltu lainsäädäntöä ja alan vaatimuksia silmällä pitäen. Valitset vain tuoteryhmän ja analyysitiheyden ja me hoidamme loput.
Tukipalvelut: enemmän kuin pelkkä analyysi
Laadunhallinnan osaamisen ansiosta voimme tarjota lisäarvopalveluita, jotka tukevat toimintaasi:
Autamme sinua hyödyntämään analytiikkaa aidosti liiketoiminnan tukena.
Meillä asiakas ei ole bulkkia
Olemme yrittäjävetoisesti toimiva laboratorio – emme osa globaalia konsernia tai julkista organisaatiota. Meille jokainen asiakas on tärkeä, ja se näkyy palvelussamme. Elämme tyytyväisistä asiakkaista ja teemme työmme sen mukaisesti.
Suunnitellaan yhdessä tarpeisiisi sopiva kokonaisuus
Luota asiantuntemukseemme, kuten lukuisat teollisuuslaitokset ja laboratoriot ovat tehneet jo vuosikymmenten ajan. Ota yhteyttä jo tänään, niin rakennetaan juuri sinun tarpeisiisi sopiva analyysikokonaisuus
*Net-Foodlab Oy:n Laboratorio on FINAS-akkreditointipalvelun akkreditoima testauslaboratorio T205, akkreditointivaatimus SFS-EN ISO/IEC17025. Tiedot akkreditoituun pätevyysalueeseen sisältyvästä toiminnasta ja toimipaikoista ovat nähtävissä verkkosivuilta www.finas.fi.

